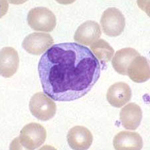

1. Stijging
Verhoging van de concentratie monocyten (> 0,8x109/l) wordt gezien bij bacteriële infecties, vooral tuberculose, sommige parasitaire infecties, bij de ziekte van Hodgkin en andere tumoren. Bij chronische neutropenie treedt als compensatie vaak monocytose op. Monocytose kan ook onderdeel zijn van een maligne bloedziekte zoals chronisch en acute myeloïde leukemie.
2. Daling
In de meeste gevallen van monopenie bestaat tegelijkertijd en door dezelfde oorzaak ook een neutropenie. De bekendste oorzaak van geïsoleerde monopenie is hairy cell leukemie.
Verhoging van de concentratie monocyten (> 0,8x109/l) wordt gezien bij bacteriële infecties, vooral tuberculose, sommige parasitaire infecties, bij de ziekte van Hodgkin en andere tumoren. Bij chronische neutropenie treedt als compensatie vaak monocytose op. Monocytose kan ook onderdeel zijn van een maligne bloedziekte zoals chronisch en acute myeloïde leukemie.
2. Daling
In de meeste gevallen van monopenie bestaat tegelijkertijd en door dezelfde oorzaak ook een neutropenie. De bekendste oorzaak van geïsoleerde monopenie is hairy cell leukemie.